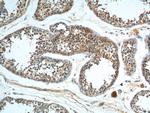
GPR22 Antibody in Immunohistochemistry (Paraffin) (IHC (P))

Search
Proteintech
GPR22 Polyclonal Antibody
{{$productOrderCtrl.translations['antibody.pdp.commerceCard.promotion.promotions']}}
{{$productOrderCtrl.translations['antibody.pdp.commerceCard.promotion.viewpromo']}}
{{$productOrderCtrl.translations['antibody.pdp.commerceCard.promotion.promocode']}}: {{promo.promoCode}} {{promo.promoTitle}} {{promo.promoDescription}}. {{$productOrderCtrl.translations['antibody.pdp.commerceCard.promotion.learnmore']}}
产品信息
19951-1-AP
种属反应
宿主/亚型
分类
类型
抗原
偶联物
形式
浓度
规格
纯化类型
保存液
内含物
保存条件
运输条件
产品详细信息
The antibody recognize the C-term of GPR22.
靶标信息
The G-protein-coupled receptor (GPCR) superfamily is comprised of an estimated 600-1, 000 members and is the largest known class of molecular targets with proven therapeutic value. GPR22 is an orphan G-protein-coupled receptor, belonging to the class A rhodopsin-like GPCRs. GPR22 is highly expressed in several human brain regions, heart and coronary arteries. GPR22 expression is also observed in normal pancreas and in pancreatic, colorectal, prostate and liver cancer.
仅用于科研。不用于诊断过程。未经明确授权不得转售。
篇参考文献 (0)
生物信息学
蛋白别名: G-protein coupled receptor 22; MGC129847; probable G-protein coupled receptor 22; tcag7.108; unnamed protein product
基因别名: 2900068K05Rik; AW061316; GPR22
UniProt ID: (Human) Q99680, (Rat) D4A3U0, (Mouse) Q8BZL4
Entrez Gene ID: (Human) 2845, (Rat) 298944, (Mouse) 73010